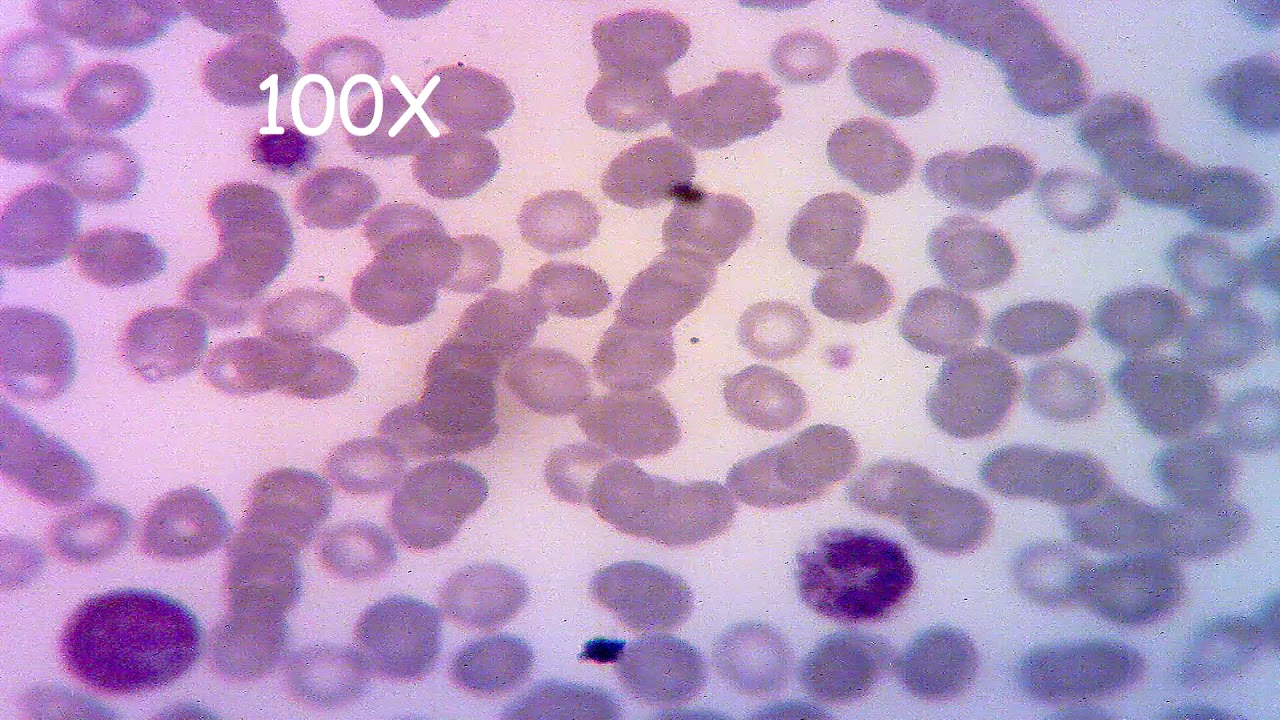

Descubre la importancia del tornillo macrométrico en el microscopio: funciones y usos clave
El tornillo macrométrico es una pieza fundamental en el funcionamiento de un microscopio, ya que permite realizar ajustes precisos en el enfoque de la muestra. Su diseño y características lo convierten en una herramienta esencial …